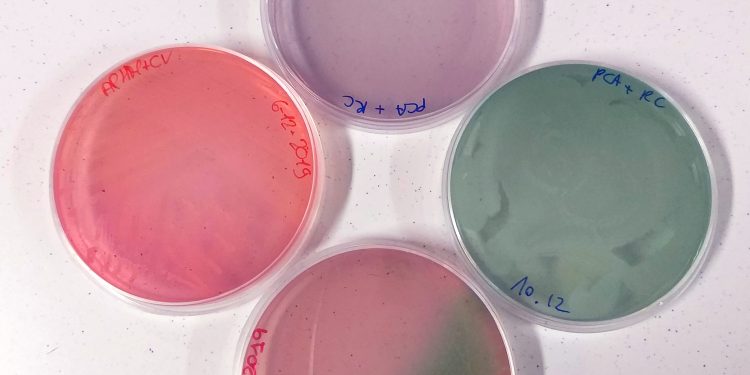
FUTURA. Il nostro terreno di coltura: una storia di patate, cavolo rosso e lockdown

Alla scuola Desanctis Deledda abbiamo il “nostro” terreno di coltura per microrganismi. E per raccontarne la genesi, bisogna raccontare una storia che parla di patate, cavolo rosso e lockdown. Ma anche di entusiasmo e collaborazione tra studenti e insegnanti.
Dicembre 2019. Periodo di orientamento in ingresso, oltre alle attività in classe e laboratorio, la professoressa Daniela Fadda (insegnante di microbiologia nel nostro istituto) girava le scuole del territorio con i suoi studenti, muniti di litri di succo di cavolo rosso per stupire i ragazzi con l’arcobaleno nascosto in questo fantastico ortaggio, che cambia colore in risposta al pH con sfumature che vanno dal rosso al giallo, passando per viola, blu, verde acqua e verde oliva.
Durante la preparazione dell’Open Day, la docente discuteva con i suoi studenti di quarta le attività da organizzare per accogliere e coinvolgere i visitatori della scuola.
Erano reduci da due esercitazioni un po’ particolari: la prima, la preparazione di un terreno di coltura per miceti (lieviti e muffe) a base di patate, durante la quale gli studenti avevano dovuto pelare, tagliare e bollire queste ultime. Attività tesa a renderli più consapevoli della composizione dei terreni di coltura…pelando patate c’è tutto il tempo per riflettere su ciò che si sta facendo, molto più che pesando delle polveri come di solito si fa con i terreni liofilizzati. Nessuna originalità, una ricetta
trovata su un sito americano dedicato alla didattica delle scienze. La seconda esercitazione, efficacia del lavaggio delle mani con diversi metodi: gli studenti avevano a disposizione due piastre, e ciascuno di loro doveva poggiare i polpastrelli su una piastra prima di lavarsi le mani, e sull’altra dopo lavate. Esercitazione già abbondantemente collaudata durante l’attività in Università della professoressa. Sull’onda dell’entusiasmo per i risultati di quest’ultima esercitazione, una studentessa ha avanzato una bellissima proposta per l’Open Day: “Prof, perché non facciamo mettere le dita sulla piastra a ciascun ragazzino che viene in visita? Così può portarla a casa e osservare i suoi germi crescere!” Grande idea. Entusiasmo unanime. Però…i terreni di coltura più interessanti per i ragazzi
sono quelli colorati…e nei terreni industriali i coloranti, o gli indicatori di pH, sono irrimediabilmente tossici. Non si potevano certamente consegnare materiali pericolosi ai visitatori. Quindi, “Vada per le piastre ma non potranno essere colorate”. Delusione generale dei ragazzi: “Ma sono noiose. Un terreno trasparente, giallino…che tristezza”. Poi…uno studente ha avuto una grande intuizione: “E se mettessimo il cavolo rosso nel terreno che abbiamo fatto con le patate? Non c’è
niente di pericoloso e abbiamo l’indicatore di pH!”. Geniale. Ha lasciato a bocca aperta pure la professoressa: “Fabio, sei un genio. Il cavolo rosso nel terreno!” Si, ma come si poteva procedere? Inoltre bisognava essere sicuri che non ostacolasse la crescita dei microrganismi.
Da quel momento sono cominciati i tentativi ed errori: hanno provato a sostituire una parte dell’acqua con l’estratto di cavolo, tentando percentuali crescenti. Il risultato era incoraggiante: hanno escluso un effetto tossico del succo di cavolo, anzi la sua presenza sembrava favorire la crescita di lieviti e bacilli sporigeni ambientali, con risultati spettacolari: il viraggio del terreno in risposta al metabolismo dei diversi microrganismi creava veri e propri quadri astratti.
Ma il problema di fondo restava il colore: troppo tenue. Sono così arrivati a sostituire metà del liquido con estratto di cavolo, e si sono dovuti accontentare dei risultati preliminari fatti di pallide sfumature di viola, rosso e verde.

Ma nessuno di loro si dava pace, docente e ragazzi. La didattica li costringeva a passare ad altro, ma ogni tanto arrivava un nuovo suggerimento: e se concentrassimo il succo? E se provassimo un’estrazione in alcool? Tentativi rimasti in sospeso, per il momento. L’anno scolastico è finito, e ne è arrivato un altro tristemente peculiare: il COVID ha rinchiuso tutti a casa e costretto le scuole alla didattica a distanza.
Con la nuova quarta, le belle lezioni in collegamento non mancavano, ma aleggiava un sentimento comune: “Prof, quanto ci manca il laboratorio”. Mancava anche alla professoressa. Così, ha lanciato una proposta: didattica a distanza, laboratorio a distanza. “Ragazzi, trasformiamo le nostre case in laboratori. Guardatevi intorno, cercate materiali che possano essere fonte di nutrimento per microrganismi, stilate i protocolli e li discutiamo insieme”.
E’ stato esaltante, da questa sorta di gara sono scaturiti terreni improbabili, i ragazzi hanno bollito di tutto: caffè, olive, zucchine, pollo…saccheggiato le farine delle cucine casalinghe, monopolizzato le pentole a pressione (per sterilizzare i terreni) e inventato modi creativi per costruire anse e becchi bunsen. In tutto questo fermento si è fatta strada un’idea per il “loro” terreno al cavolo rosso: l’ingrediente “magico” andava bollito insieme alle patate. Solo così potevano sperare di ottenere una colorazione soddisfacente. La docente si è occupata del “fine tuning” per determinare le quantità relative degli ingredienti, aggiustando via via le dosi in base ai risultati delle semine e alla risposta di diversi microrganismi. Alla fine eccolo, bello come il sole, il loro terreno. Non poteva definirsi più “loro” di così, anzi adesso
è nostro, il “terreno del Tecnologico”, il “Terreno del De Sanctis Deledda”, ne erano (e noi tutti ne siamo) giustamente orgogliosi: è fatto con materiali che verrebbero smaltiti, scarti di cucina, per cui è atossico, ecologico, economico e alla portata di tutti, e soprattutto…bellissimo.

E siccome la scienza e la bellezza appartengono a tutti e vanno condivise, ecco la ricetta del TERRENO RCA DESANCTIS DELEDDA (Red Cabbage Agar)
- patate pelate 200 g
- foglie di cavolo viola 100 g
- saccarosio o glucosio 20 g
- agar agar 20 g
- acqua deionizzata 1000 ml

Tagliare le patate e il cavolo in pezzi piccolissimi (conviene usare una mandolina). Bollire le verdure per almeno 30 minuti dal bollore, o finchè il cavolo risulta quasi bianco. Filtrare il liquido ottenuto attraverso una garza a maglie fitte (patate e cavoli possono essere recuperati per un’insalata o un purè!) e aggiungere lo zucchero e l’agar. Portare a ebollizione per sciogliere l’agar. Distribuire in contenitori (vasetti con tappo) puliti e sterilizzare in autoclave. In mancanza di autoclave, si può
sterilizzare in pentola a pressione. Questo terreno è ideale per la crescita di microrganismi ambientali poco esigenti come muffe e lieviti, e anche molti batteri sporigeni.
ATTENZIONE: tutti gli strumenti e le superfici che verranno in contatto con il liquido e il terreno dovranno essere pulitissimi e privi di tracce di detergenti, che farebbero virare il terreno e risulterebbero tossici per i microrganismi, anche se presenti in tracce per noi trascurabili.
RINGRAZIAMENTI.
Grazie alla natura, mai avara di meraviglie.
Grazie alla 4L dell’indirizzo Tecnico Tecnologico Biosanitario, A.S. 2018/19, con cui tutto è iniziato, e in particolare ad Alessia Zanda per l’idea di regalare le piastre durante gli Open Day e a Fabio Mulas per il colpo di genio del cavolo rosso nel terreno.
Grazie alla 4L dell’indirizzo Tecnico Tecnologico Biosanitario, A.S. 2019/20, appassionati sperimentatori di laboratorio in lockdown, fondamentali nella messa a punto definitiva del terreno.
Questa nuova rubrica nasce con la precisa volontà di ascoltare il punto di vista delle persone più giovani su tanti temi, grandi e piccoli. È una generazione spesso trascurata nel dibattito politico e altrettanto spesso è descritta come poco impegnata, disinteressata e senza aspirazioni. Noi pensiamo tutto il contrario e abbiamo deciso di dare loro voce con questo spazio.